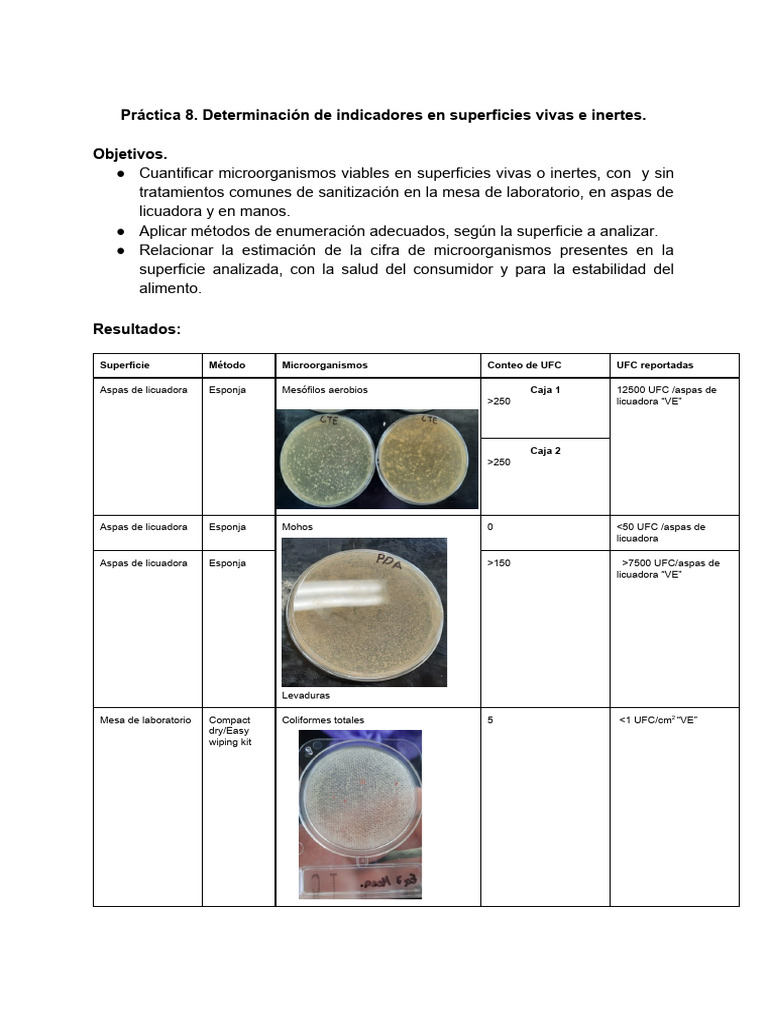
an-lisis-de-superficies-vivas-e-inertes-pdf-organismos-microbiolog-a

Precios De La Usda are the perfect solution for staying organized and handling your time effectively. These calendars come in a range of formats, including monthly, weekly, and yearly layouts, permitting you to pick the one that fits your preparation design. Whether you're tracking visits, setting objectives, or managing your family's schedule, a printable calendar is an easy yet effective tool. With adjustable designs varying from minimalistic to dynamic themes, there's an option to fit everybody's taste.
Downloading and printing a calendar is quick and hassle-free. You can print them in the house, work, or a regional store, making them available anytime you require them. Numerous templates even include pre-marked vacations and special events, saving you time. Start preparing your days with a Precios De La Usda and delight in the advantages of a more orderly and productive life!
Precios De La Usda
Precios De La Usda
Print and color our free printable United States Flag coloring page for kids perfect for classrooms and at home art activities Print today Our free printable American flag collection has accurate flags of 4 different sizes (plus a blank one to color in!) which can be used in many different ways.
FREE Printable US Flags American Flag color book pages
TABLA USDA 1 1 Comprimido PDF Dieta Alimentos
Precios De La UsdaView FULL size and PRINT (PDF)USA flag coloring page. KinderArt.comWhat is this? Report Ad. Click here for Printable PDF. Download free United States flag graphics and printables including vector images clip art and more Many different formats and sizes are available
Salute the stars and stripes with these 20 American flag coloring pages that are all free to download or print! The American flag has long ... Ejercicio Para Ni os De La Tabla Del 2 Actividades De Multiplicaci n Ya Conoces Nuestra Promoci n Churrascaria Do Brasil Facebook
Printable American Flag
An lisis De Superficies Vivas E Inertes PDF Organismos Microbiolog a
Choose from 20 FREE flag coloring pages and templates that include hearts eagles the Betsy Ross flag and more 100 FREE Print from home Tramites Y Requisitos Para Viajar Con Tu Perro A EUA Desde M xico
The flag of United States Free to download and print Conoces Las Tablas De La USDA YouTube NOTICIERO 1ERA EDICI N NOTICIERO 1ERA EDICI N By Heber Garc a
PORCIONES LISTA DE INTERCAMBIO USDA PDF Mantequilla Alimentos
Mapa Del Uso De La Tierras De Guatemala PDF
Gu a De Lista De Intercambio De Alimentos Peruanos Compartir PDF
Tabla Composici n De Alimentos Tcqa Usfq PDF Alimentos Etiqueta
Lista De Intercambio De Alimentos Hospital SN Juan De Dios PDF

OFERTAS DE FLORES 2023 Ropa De Mujer Ni os Y Hombres YouTube

DETERMINACI N DE LA CLASE TEXTURAL DEL SUELO MEDIANTE EL TRI NGULO DE

Tramites Y Requisitos Para Viajar Con Tu Perro A EUA Desde M xico

About Ag Biz Digital Hub
SC Agromec Moara Vlasiei SC Agromec Moara Vlasiei SRL